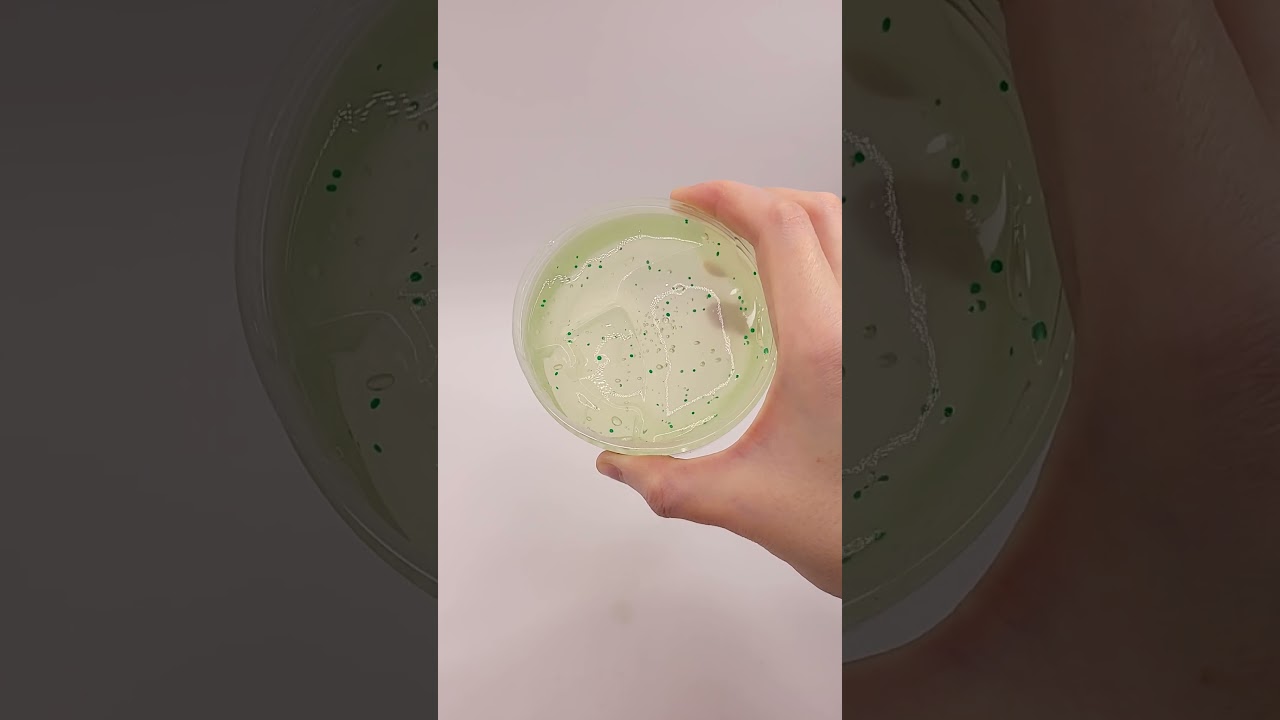

YouTube · July 16, 2021
YouTube · October 5, 2024

YouTube · October 10, 2017

YouTube · September 21, 2017

YouTube · February 19, 2025

YouTube · February 26, 2025

YouTube · May 19, 2025

YouTube · April 15, 2025

YouTube · January 27, 2025